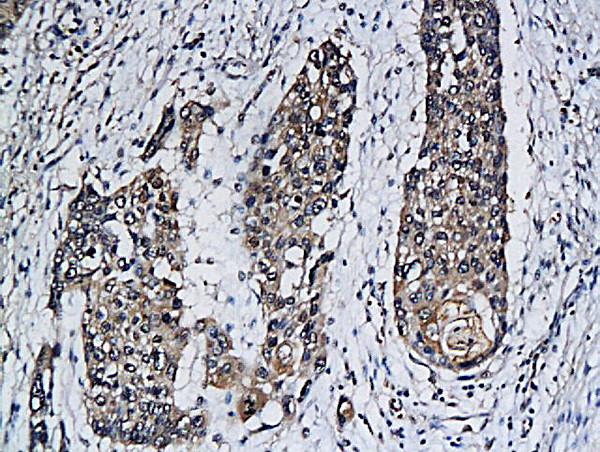
PDL2/B7-DC Antibody in Immunohistochemistry (Paraffin) (IHC (P))

Search
Bioss
PDL2/B7-DC Polyclonal Antibody
{{$productOrderCtrl.translations['antibody.pdp.commerceCard.promotion.promotions']}}
{{$productOrderCtrl.translations['antibody.pdp.commerceCard.promotion.viewpromo']}}
{{$productOrderCtrl.translations['antibody.pdp.commerceCard.promotion.promocode']}}: {{promo.promoCode}} {{promo.promoTitle}} {{promo.promoDescription}}. {{$productOrderCtrl.translations['antibody.pdp.commerceCard.promotion.learnmore']}}
产品信息
BS-1868R
种属反应
宿主/亚型
分类
类型
抗原
偶联物
形式
浓度
规格
纯化类型
保存液
内含物
保存条件
运输条件
靶标信息
Programmed death-ligand 2 (PD-L2), or B7-DC, is a member of the B7 ligand family within the immunoglobulin superfamily that, along with programmed death-ligand 1 (PD-L1), acts as a ligand for programmed cell death protein 1 (PD-1). Though expressed primarily in dendritic cells, PD-L2 expression can be induced on a wide variety of immune and non-immune cells depending on the microenvironment. PD-L2 expression is particularly upregulated in the presence of Th2 cytokine, IL-4, as well as Th1 cytokines, TNF-alpha and IFN-gamma to a lesser degree. While generally expressed at lower levels compared to PD-L1, PD-L2 demonstrates a 2 to 6 times higher relative affinity to PD-1 than PD-L1. PD-1 and its ligands are referred to as inhibitory immune checkpoint molecules in that they provide useful negative feedback during physiological homeostasis. Ligation of PD-L2 or PD-L1 inhibits activation, proliferation, and cytokine secretion (e.g. IFN-gamma, IL-10) in T cells, ultimately dampening immune response. Conversely, studies have shown that PD-L2 can also stimulate T cell proliferation and cytokine production, even in PD-1-deficient T cells, suggesting additional receptors. Recent studies have concluded that PD-L2 also binds to a second receptor, repulsive guidance molecule b (RGMb), which was originally identified as a receptor for bone morphogenetic proteins (BMPs). RGMb is expressed in the central nervous system, as well as in macrophages, however, its role in immunity is only beginning to emerge. Interaction between PD-L2 and RGMb regulates the development of respiratory tolerance in the lung through BMP and/or neogenin signaling pathways. The naturally occurring human PD-L2 monomer consists of a 201-amino-acid extracellular domain, a 21-amino-acid transmembrane domain, and a 32-amino-acid cytoplasmic domain.
仅用于科研。不用于诊断过程。未经明确授权不得转售。
篇参考文献 (0)
生物信息学
蛋白别名: B7 dendritic cell molecule; B7-DC; BTDC; costimulatory molecule; Butyrophilin B7-DC; butyrophilin-like protein; CD273; MGC124039; MGC124040; PD-1 ligand 2; PD-1-ligand 2; PD-L2; PD1 ligand 2; PDCD1 ligand 2; Programmed cell death 1 ligand 2; programmed death ligand 2
基因别名: B7-DC; B7DC; bA574F11.2; Btdc; CD273; F730015O22Rik; PD-L2; PDCD1L2; PDCD1LG2; PDL2
UniProt ID: (Human) Q9BQ51, (Mouse) Q9WUL5
Entrez Gene ID: (Human) 80380, (Rat) 309304, (Mouse) 58205